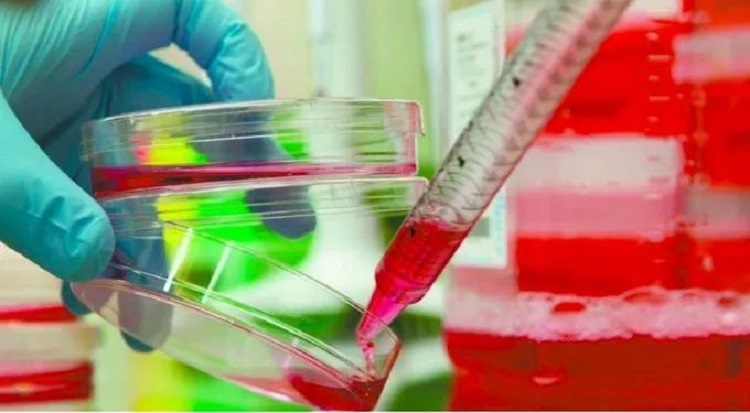

@SadatAfsar | Twitter
当地时间2月20日(周四)晚,美国德州基因工程公司Greffex Inc.称已经完成新型肺炎疫苗的研发。该公司首席执行官约翰·普莱斯(John Price)表示,如果该疫苗最终获得批准,愿意免费赠送给受疫情影响最严重的国家。
该公司表示,接下来将与美国食品与药物监督管理局(Food and Drug Administration,简称FDA)合作对该疫苗进行动物试验。普莱斯称,该疫苗的研发并没有使用现有的新冠病毒,而是使用了广泛用于对抗传染性疾病和癌症的腺病毒的载体疫苗。
普莱斯认为,对于疫苗研发来说,关键在于能否成规模生产足够的试剂量以及快速有效地测试疫苗并将疫苗送到病人手中。普莱斯 称,如果该疫苗最终获得批准,该公司愿意将疫苗免费送给疫情影响最严重的国家。
据了解,该疫苗的研发经费来源于Greffex Inc.公司去年9月从美国国立卫生研究院(National Institute of Health,简称NIH)的国家过敏与传染病研究所(National Institute for Allergy and Infectious Diseases,简称NAID)获得的 1890 万美元资金支持。
Greffex Inc.是一家总部位于美国德州的基因工程公司,成立于1999 年,主要致力包括疫苗、器官移植等基因疗法。该公司开发出了一套名为GREVAX的通用性基因药物研发平台,用于精简基因疗法的设计、研发和生产整个流程。
@AadilAhadBaloc1 | Twitter
@AadilAhadBaloc1 | Twitter
此前,另一家美国生物医药技术公司Moderna也宣布,正在进行新冠肺炎疫苗的研发。NAID主任安东尼·S·福西(Anthony S. Fauci)此前在接受媒体采访时曾表示,希望在大约 3 个月后,能够进行第一阶段的人体试验。
未经允许不得转载:城市新闻网icitynews » 德州基因工程公司称已完成新冠肺炎疫苗研发 称将免费赠疫情严重的地区








































